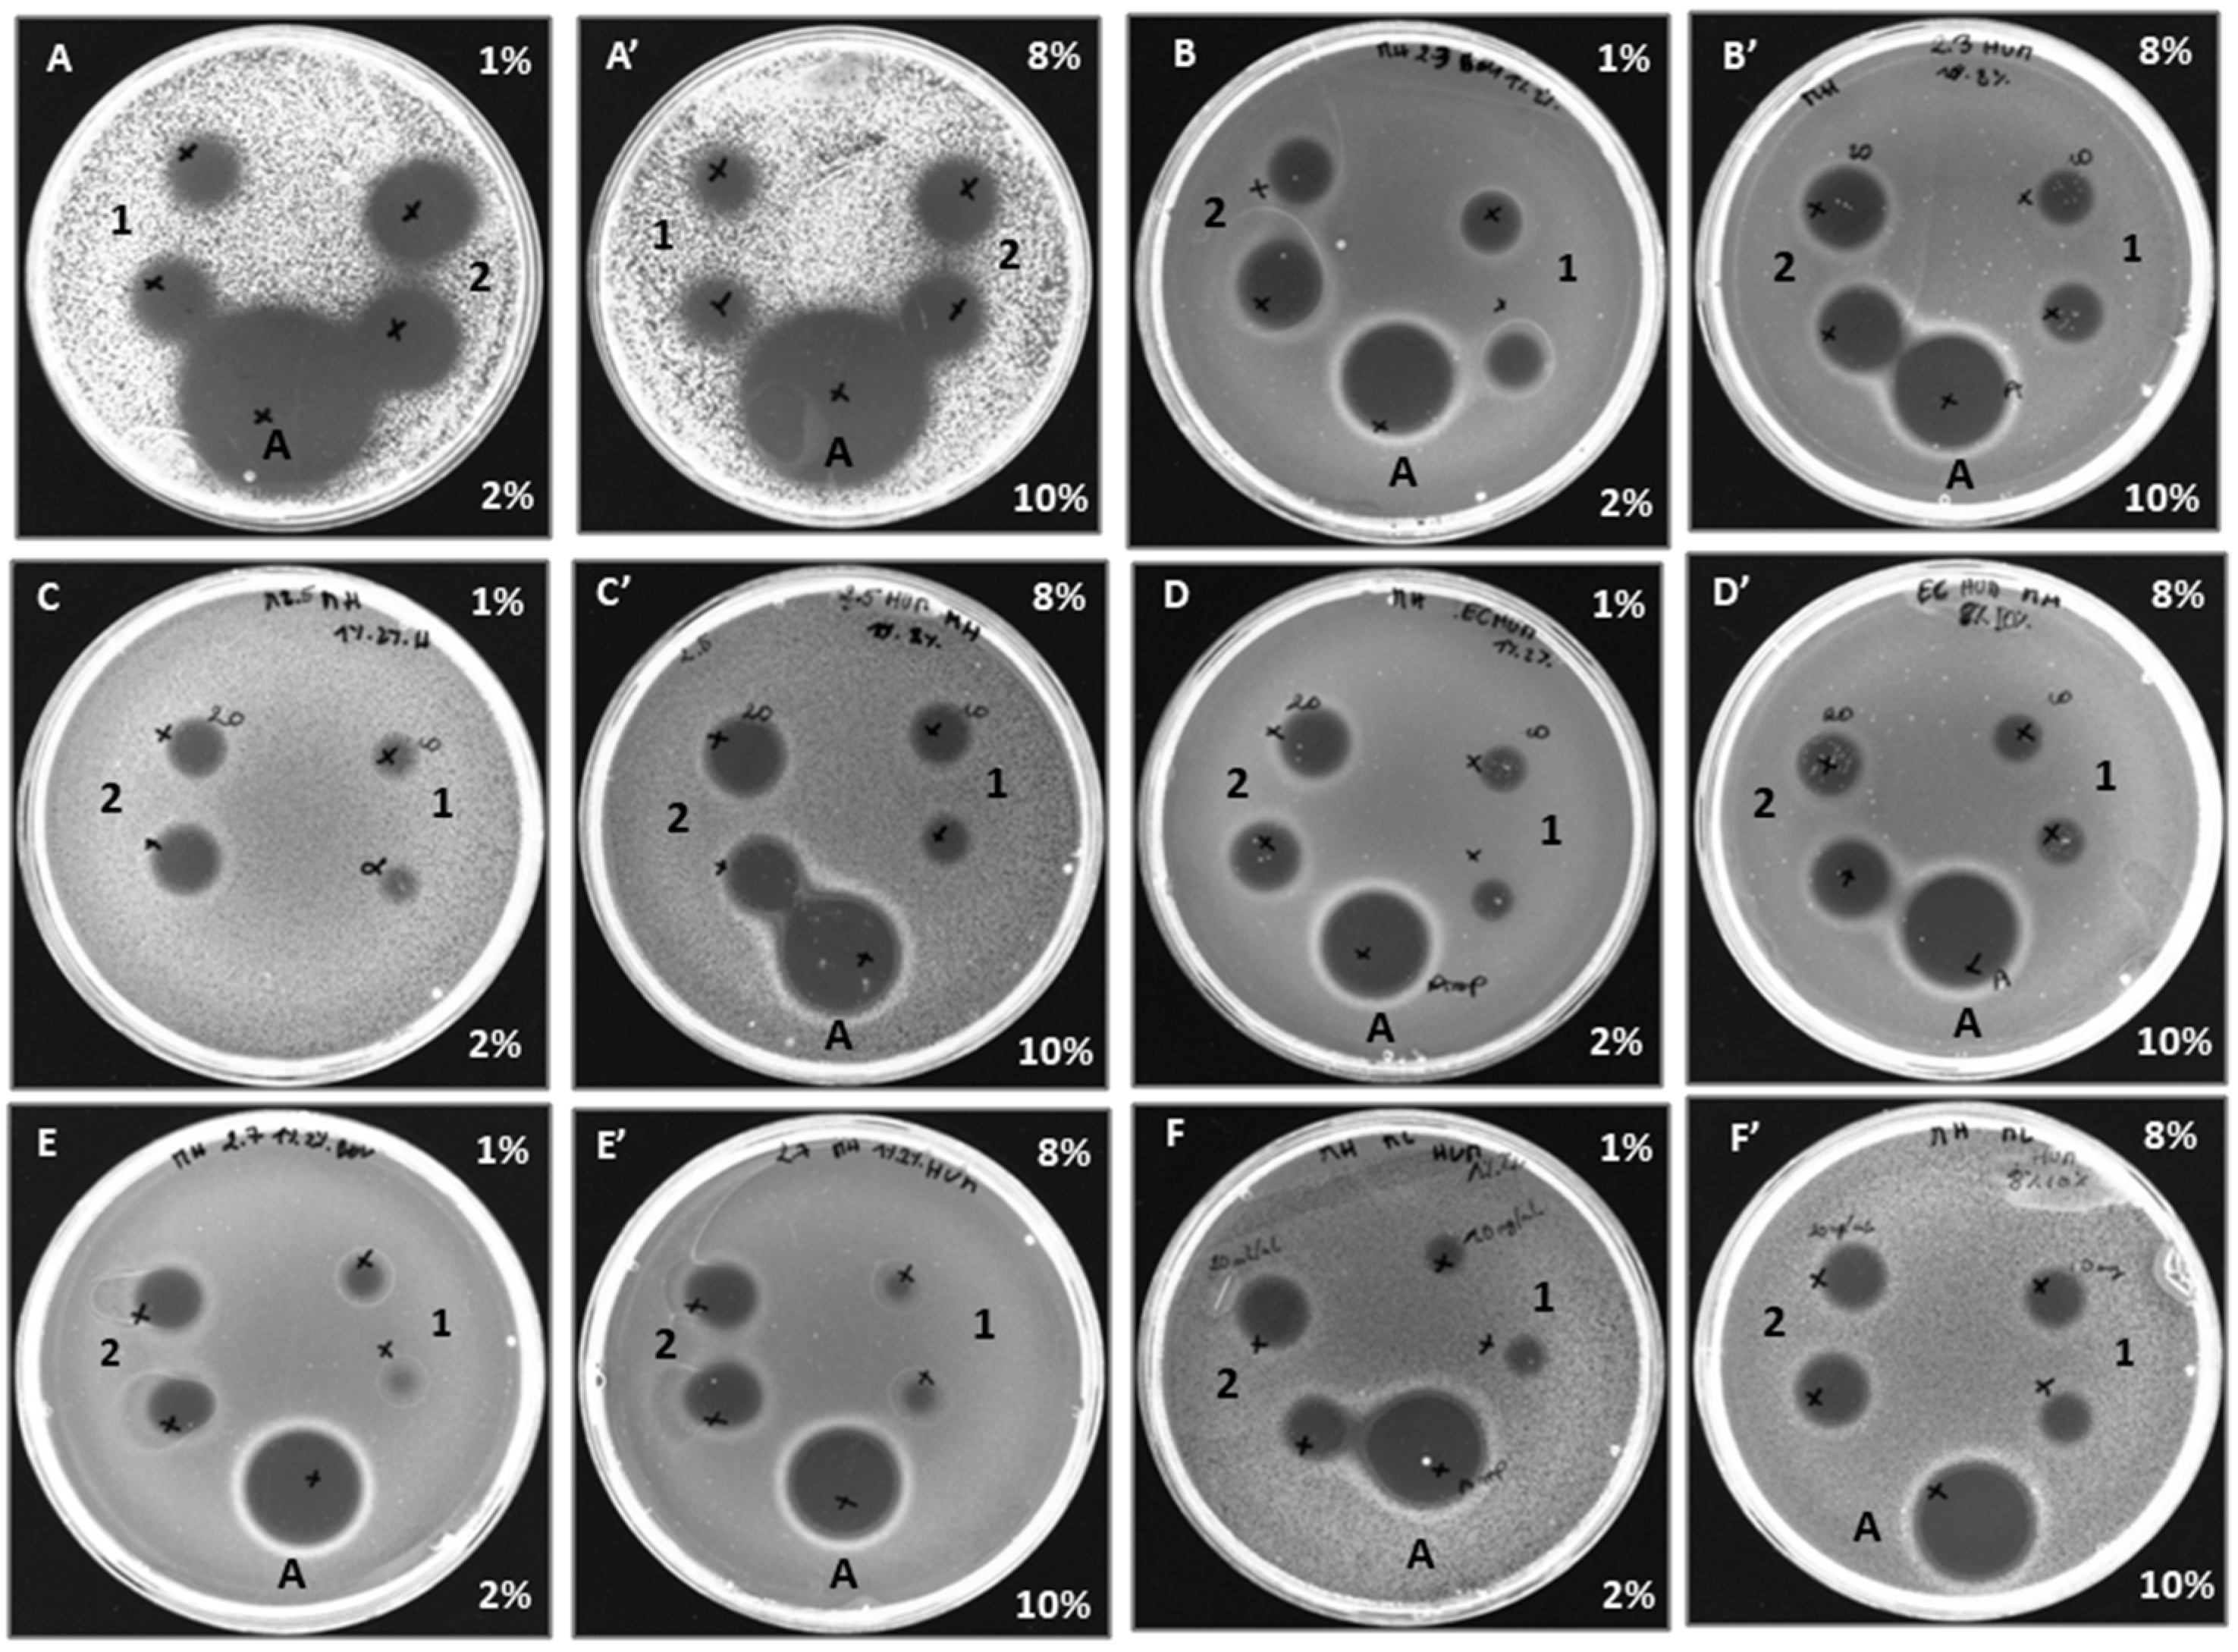

Comparison of the Bioactive Properties of Human and Bovine Hemoglobin Hydrolysates Obtained by Enzymatic Hydrolysis: Antimicrobial and Antioxidant Potential of the Active Peptide α137-141
Abstract
:1. Introduction
2. Results
2.1. Biological Activities of the Human and Bovine Hydrolysates
2.1.1. Antibacterial Activity
AntimicrobialTest on Petri Dish
MIC Determination of Antibacterial Hemoglobin Hydrolysates
2.1.2. Antioxidant Activities of Human and Bovine Hemoglobin Hydrolysates
β-Carotene Bleaching Inhibition Activity
DPPH’s Free Radical Scavenging Capacity
Antioxidant Properties Products by ABTS Assay
Evaluation of Total Antioxidant Capacity
2.2. Study of the Antimicrobial, Antioxidant Activity and Peptidomic Analysis of Fractions of Peptide Hydrolysates
3. Discussion
3.1. Analysis of the Antimicrobial and Antioxidant Activity of Bovine and Human Hemoglobin Hydrolysates and Their Peptide Fractions
3.2. Identification of Antimicrobial Peptides Resulting from the Hydrolysis of Human and Bovine Hemoglobin
4. Materials and Methods
4.1. Materials: Chemicals and Cultures Used
4.2. Preparation of Bovine Hemoglobin Hydrolysates
4.2.1. Preparation of the Stock Solution
4.2.2. Hydrolysis Process
4.2.3. Fractionation of Peptide Hydrolysates by Semi-Preparative HPLC
4.2.4. Analysis RP-UPLC, Mass Spectrometry Analysis
4.3. Determination of the Hydrolysates Bioactivity
4.3.1. Antibacterial Activity
Antimicrobial Test on Petri Dish: Agar Diffusion Method
Determination of the Minimal Inhibitory Concentration (MIC)
4.3.2. Antioxidant Activity
Antioxidant Assay Using the β-Carotene Bleaching Method
DPPH Radical Scavenging Capacity
Antioxidant Properties Products by ABTS Assay
Evaluation of Total Antioxidant Capacity
4.4. Statistical Analyses
5. Conclusions
Author Contributions
Funding
Institutional Review Board Statement
Informed Consent Statement
Acknowledgments
Conflicts of Interest
References
- Bah, C.S.; Bekhit, A.E.-D.A.; Carne, A.; McConnell, M.A. Slaughterhouse blood: An emerging source of bioactive compounds. Compr. Rev. Food Sci. Food Saf. 2013, 12, 314–331. [Google Scholar] [CrossRef]
- De Castro, R.J.S.; Sato, H.H. Biologically active peptides: Processes for their generation, purification and identification and applications as natural additives in the food and pharmaceutical industries. Food Res. Int. 2015, 74, 185–198. [Google Scholar] [CrossRef]
- Przybylski, R.; Firdaous, L.; Châtaigné, G.; Dhulster, P.; Nedjar, N. Production of an antimicrobial peptide derived from slaughterhouse by-product and its potential application on meat as preservative. Food Chem. 2016, 211, 306–313. [Google Scholar] [CrossRef]
- Sasakawa, S. Studies on Hemoglobin VI. Amino Acid Compositions of the Fractionated Bovine Globin α and β. J. Biochem. 1961, 50, 345–351. [Google Scholar] [CrossRef] [PubMed]
- Schally, A.V.; Baba, Y.; Nair, R.M.G.; Bennett, C.D. The amino acid sequence of a peptide with growth hormone-releasing activity isolated from porcine hypothalamus. J. Biol. Chem. 1971, 246, 6647–6650. [Google Scholar] [CrossRef] [PubMed]
- Takagi, H.; Shiomi, H.; Ueda, H.; Amano, H. A novel analgesic dipeptide from bovine brain is a possible Met-enkephalin releaser. Nature 1979, 282, 410–412. [Google Scholar] [CrossRef]
- Fukui, K.; Shiomi, H.; Takagi, H.; Hayashi, K.; Kiso, Y.; Kitagawa, K. Isolation from bovine brain of a novel analgesic pentapeptide, neo-kyotorphin, containing the Tyr-Arg (kyotorphin) unit. Neuropharmacology 1983, 22, 191–196. [Google Scholar] [CrossRef]
- Zhao, Q.; Piot, J.M. Neokyotorphin formation and quantitative evolution following human hemoglobin hydrolysis with cathepsin D. Peptides 1998, 19, 759–766. [Google Scholar] [CrossRef]
- Brantl, V.; Gramsch, C.; Lottspeich, F.; Mertz, R.; Jaeger, K.-H.; Herz, A. Novel opioid peptides defived from hemoglobin: Hemorphins. Eur. J. Pharmacol. 1986, 125, 309–310. [Google Scholar] [CrossRef]
- Ivanov, V.T.; Karelin, A.A.; Philippova, M.M.; Nazimov, I.V.; Pletnev, V.Z. Hemoglobin as a source of endogenous bioactive peptides: The concept of tissue-specific peptide pool. Pept. Sci. 1997, 43, 171–188. [Google Scholar] [CrossRef]
- Lignot, B.; Froidevaux, R.; Nedjar-Arroume, N.; Guillochon, D. Solvent effect on kinetics of appearance of neokyotorphin, VV-haemorphin-4 and a bradykinin-potentiating peptide in the course of peptic hydrolysis of bovine haemoglobin. Biotechnol. Appl. Biochem. 1999, 30, 201–207. [Google Scholar] [PubMed]
- Zhao, Q.; Piot, J.M. Investigation of inhibition angiotensin-converting enzyme (ACE) activity and opioid activity of two hemorphins, LVV-hemorphin-5 and VV-hemorphin-5, isolated from a defined peptic hydrolysate of bovine hemoglobin. Neuropeptides 1997, 31, 147–153. [Google Scholar] [CrossRef] [PubMed]
- Vercaigne-Marko, D.; Kosciarz, E.; Nedjar-Arroume, N.; Guillochon, D. Improvement of Staphylococcus aureus-V8-protease hydrolysis of bovine haemoglobin by its adsorption on to a solid phase in the presence of SDS: Peptide mapping and obtention of two haemopoietic peptides. Biotechnol. Appl. Biochem. 2000, 31, 127–134. [Google Scholar] [CrossRef] [PubMed]
- Adje, E.Y.; Balti, R.; Kouach, M.; Guillochon, D.; Nedjar-Arroume, N. α 67-106 of bovine hemoglobin: A new family of antimicrobial and angiotensin I-converting enzyme inhibitory peptides. Eur. Food Res. Technol. 2011, 232, 637–646. [Google Scholar] [CrossRef]
- Daoud, R.; Dubois, V.; Bors-Dodita, L.; Nedjar-Arroume, N.; Krier, F.; Chihib, N.-E.; Mary, P.; Kouach, M.; Briand, G.; Guillochon, D. New antibacterial peptide derived from bovine hemoglobin. Peptides 2005, 26, 713–719. [Google Scholar] [CrossRef]
- Nedjar-Arroume, N.; Dubois-Delval, V.; Adje, E.Y.; Traisnel, J.; Krier, F.; Mary, P.; Kouach, M.; Briand, G.; Guillochon, D. Bovine hemoglobin: An attractive source of antibacterial peptides. Peptides 2008, 29, 969–977. [Google Scholar] [CrossRef]
- Choisnard, L.; Froidevaux, R.; Nedjar-Arroume, N.; Lignot, B.; Vercaigne-Marko, D.; Krier, F.; Dhulster, P.; Guillochon, D. Kinetic study of the appearance of an anti-bacterial peptide in the course of bovine haemoglobin peptic hydrolysis. Biotechnol. Appl. Biochem. 2002, 36, 187–194. [Google Scholar] [CrossRef]
- Parish, C.A.; Jiang, H.; Tokiwa, Y.; Berova, N.; Nakanishi, K.; McCabe, D.; Zuckerman, W.; Xia, M.M.; Gabay, J.E. Broad-spectrum antimicrobial activity of hemoglobin. Bioorg. Med. Chem. 2001, 9, 377–382. [Google Scholar] [CrossRef]
- Liepke, C.; Baxmann, S.; Heine, C.; Breithaupt, N.; Ständker, L.; Forssmann, W.-G. Human hemoglobin-derived peptides exhibit antimicrobial activity: A class of host defense peptides. J. Chromatogr. B 2003, 791, 345–356. [Google Scholar] [CrossRef]
- Gomes de Melo, J.; de Sousa Araújo, T.A.; Thijan Nobre de Almeida e Castro, V.; Lyra de Vasconcelos Cabral, D.; Do Desterro Rodrigues, M.; Carneiro do Nascimento, S.; Cavalcanti de Amorim, E.L.; De Albuquerque, U.P. Antiproliferative activity, antioxidant capacity and tannin content in plants of semi-arid northeastern Brazil. Molecules 2010, 15, 8534–8542. [Google Scholar] [CrossRef]
- Catiau, L.; Traisnel, J.; Delval-Dubois, V.; Chihib, N.-E.; Guillochon, D.; Nedjar-Arroume, N. Minimal antimicrobial peptidic sequence from hemoglobin alpha-chain: KYR. Peptides 2011, 32, 633–638. [Google Scholar] [CrossRef]
- Nedjar-Arroume, N.; Dubois-Delval, V.; Miloudi, K.; Daoud, R.; Krier, F.; Kouach, M.; Briand, G.; Guillochon, D. Isolation and characterization of four antibacterial peptides from bovine hemoglobin. Peptides 2006, 27, 2082–2089. [Google Scholar] [CrossRef]
- Abou-Diab, M.; Thibodeau, J.; Deracinois, B.; Flahaut, C.; Fliss, I.; Dhulster, P.; Bazinet, L.; Nedjar, N. Bovine hemoglobin enzymatic hydrolysis by a new eco-efficient process-part II: Production of bioactive peptides. Membranes 2020, 10, 268. [Google Scholar] [CrossRef] [PubMed]
- Zhuang, H.; Tang, N.; Yuan, Y. Purification and identification of antioxidant peptides from corn gluten meal. J. Funct. Foods 2013, 5, 1810–1821. [Google Scholar] [CrossRef]
- Merouane, A.; Noui, A.; Ali, K.N.B.; Saadi, A. Activité antioxydante des composés phénoliques d’huile d’olive extraite par méthode traditionnelle. Int. J. Biol. Chem. Sci. 2014, 8, 1865–1870. [Google Scholar] [CrossRef]
- Molyneux, P. The use of the stable free radical diphenylpicrylhydrazyl (DPPH) for estimating antioxidant activity. Songklanakarin J. Sci. Technol. 2004, 26, 211–219. [Google Scholar]
- Re, R.; Pellegrini, N.; Proteggente, A.; Pannala, A.; Yang, M.; Rice-Evans, C. Antioxidant activity applying an improved ABTS radical cation decolorization assay. Free Radic. Biol. Med. 1999, 26, 1231–1237. [Google Scholar] [CrossRef]
- Outman, A.; Deracinois, B.; Flahaut, C.; Abou Diab, M.; Gressier, B.; Eto, B.; Nedjar, N. Potential of Human Hemoglobin as a Source of Bioactive Peptides: Comparative Study of Enzymatic Hydrolysis with Bovine Hemoglobin and Production of Active Peptide α137–141. Int. J. Mol. Sci. 2023, 24, 11921. [Google Scholar] [CrossRef]
- Abou-Diab, M.; Thibodeau, J.; Deracinois, B.; Flahaut, C.; Fliss, I.; Dhulster, P.; Nedjar, N.; Bazinet, L. Bovine Hemoglobin Enzymatic Hydrolysis by a New Ecoefficient Process—Part I: Feasibility of Electrodialysis with Bipolar Membrane and Production of Neokyotorphin (α137–141). Membranes 2020, 10, 257. [Google Scholar] [CrossRef]
- Takagi, H.; Shiomi, H.; Fukui, K.; Hayashi, K.; Kiso, Y.; Kitagawa, K. Isolation of a novel analgesic pentapeptide, neo-kyotorphin, from bovine brain. Life Sci. 1982, 31, 1733–1736. [Google Scholar] [CrossRef]
- Zhao, Q.; Sannier, F.; Piot, J.M. Kinetics of appearance of four hemorphins from bovine hemoglobin peptic hydrolysates by HPLC coupled with photodiode array detection. Biochim. Biophys. Acta BBA-Protein Struct. Mol. Enzymol. 1996, 1295, 73–80. [Google Scholar] [CrossRef]
- Adje, E.Y. Hydrolyse Ménagée de L’hémoglobine Bovine par la Pepsine Porcine en Mélanges Hydroalcooliques et Obtention D’une nouvelle Famille de Peptides Antimicrobiens. Ph.D. Thesis, Université de Lille I, Villeneuve-d’Ascq, France, 2010. [Google Scholar]
- Borch, E.; Arinder, P. Bacteriological safety issues in red meat and ready-to-eat meat products, as well as control measures. Meat Sci. 2002, 62, 381–390. [Google Scholar] [CrossRef] [PubMed]
- Froidevaux, R.; Krier, F.; Nedjar-Arroume, N.; Vercaigne-Marko, D.; Kosciarz, E.; Ruckebusch, C.; Dhulster, P.; Guillochon, D. Antibacterial activity of a pepsin-derived bovine hemoglobin fragment. FEBS Lett. 2001, 491, 159–163. [Google Scholar] [CrossRef] [PubMed]
- Marco, G.J. A rapid method for evaluation of antioxidants. J. Am. Oil Chem. Soc. 1968, 45, 594–598. [Google Scholar] [CrossRef]
- Koleva, I.I.; Van Beek, T.A.; Linssen, J.P.; de Groot, A.; Evstatieva, L.N. Screening of plant extracts for antioxidant activity: A comparative study on three testing methods. Phytochem. Anal. Int. J. Plant Chem. Biochem. Tech. 2002, 13, 8–17. [Google Scholar] [CrossRef]
- Bersuder, P.; Hole, M.; Smith, G. Antioxidants from a heated histidine-glucose model system. I: Investigation of the antioxidant role of histidine and isolation of antioxidants by high-performance liquid chromatography. J. Am. Oil Chem. Soc. 1998, 75, 181–187. [Google Scholar] [CrossRef]
- Gülçin, İ. Antioxidant properties of resveratrol: A structure—Activity insight. Innov. Food Sci. Emerg. Technol. 2010, 11, 210–218. [Google Scholar] [CrossRef]
- Maisuthisakul, P.; Pongsawatmanit, R.; Gordon, M.H. Characterization of the phytochemicals and antioxidant properties of extracts from Teaw (Cratoxylum formosum Dyer). Food Chem. 2007, 100, 1620–1629. [Google Scholar] [CrossRef]
- Prieto, P.; Pineda, M.; Aguilar, M. Spectrophotometric quantitation of antioxidant capacity through the formation of a phosphomolybdenum complex: Specific application to the determination of vitamin E. Anal Biochem. 1999, 269, 337–341. [Google Scholar] [CrossRef]

| Hemoglobin Hydrolysates | |||||||||
|---|---|---|---|---|---|---|---|---|---|
| 1% | 2% | 8% | 10% | α137-141 | |||||
| Bacteria Strains | Bovine | Human | Bovine | Human | Bovine | Human | Bovine | Human | Standard |
| Kocuriarhizophila | +++ | +++ | +++ | +++ | +++ | +++ | +++ | +++ | +++ |
| Staphylococcus aureus | +++ | +++ | +++ | +++ | +++ | ++ | +++ | ++ | +++ |
| Listeria monocytogenes | ++ | ++ | ++ | ++ | ++ | ++ | ++ | ++ | ++ |
| Escherichia coli | ++ | + | + | + | + | + | ++ | ++ | + |
| Salmonelle Newport | ++ | + | ++ | + | ++ | + | ++ | + | + |
| Micrococcus luteus | ++ | ++ | ++ | ++ | ++ | ++ | ++ | + | ++ |
| Bovine Hemoglobin Hydrolysates (mg/mL) | ||||
|---|---|---|---|---|
| Bacteria Strains | 1% | 2% | 8% | 10% |
| Kocuriarhizophila | 0.15 ± 0.0 a | 0.15 ± 0.0 a | 0.15 ± 0.0 a | 0.15 ± 0.0 a |
| Staphylococcus aureus | 0.31 ± 0.0 a | 0.31 ± 0.0 a | 0.31 ± 0.0 a | 0.31 ± 0.0 a |
| Listeria monocytogenes | 0.62 ± 0.0 a | 0.62 ± 0.0 a | 0.62 ± 0.0 a | 0.62 ± 0.0 a |
| Escherichia coli | 10 ± 0.0 a | 10 ± 0.0 a | 10 ± 0.0 a | 10 ± 0.0 a |
| Salmonelle Newport | 5 ± 0.0 b | 5 ± 0.0 b | 5 ± 0.0 b | 5 ± 0.0 b |
| Micrococcus luteus | 5 ± 0.0 a | 5 ± 0.0 a | 5 ± 0.0 a | 5 ± 0.0 a |
| Human Hemoglobin Hydrolysates (mg/mL) | ||||
| Bacteria Strains | 1% | 2% | 8% | 10% |
| Kocuriarhizophila | 0.15 ± 0.0 a | 0.15 ± 0.0 a | 0.15 ± 0.0 a | 0.15 ± 0.0 a |
| Staphylococcus aureus | 0.31 ± 0.0 a | 0.31 ± 0.0 a | 0.31 ± 0.0 a | 0.31 ± 0.0 a |
| Listeria monocytogenes | 0.62 ± 0.0 a | 0.62 ± 0.0 a | 0.62 ± 0.0 a | 0.62 ± 0.0 a |
| Escherichia coli | 10 ± 0.0 a | 10 ± 0.0 a | 10 ± 0.0 a | 10 ± 0.0 a |
| Salmonelle Newport | 10 ± 0.0 a | 10 ± 0.0 a | 10 ± 0.0 a | 10 ± 0.0 a |
| Micrococcus luteus | 5 ± 0.0 a | 5 ± 0.0 a | 5 ± 0.0 a | 5 ± 0.0 a |
| Purification | 1% | 2% | 8% | 10% | NKT | TROLOX | |
|---|---|---|---|---|---|---|---|
| IC50 (mg/mL) | Human | 3.07 ± 0.34 ns | 2.63 ± 0.31 * | 2.45 ± 0.28 * | 2.68 ± 0.32 ns | 0.83 ± 0.09 | 0.38 ± 0.03 |
| Bovine | 3.83 ± 0.40 ns | 3.26 ± 0.36 * | 3.01 ± 0.32 * | 3.22 ± 0.38 ns | |||
| TEAC | Human | 0.12 ± 0.05 ns | 0.14 ± 0.04 ns | 0.15 ± 0.05 ns | 0.14 ± 0.04 ns | 0.45 ± 0.07 | 1 |
| Bovine | 0.10 ± 0.02 ns | 0.12 ± 0.04 ns | 0.13 ± 0.04 ns | 0.12 ± 0.03 ns | |||
| Purification | 1% | 2% | 8% | 10% | NKT | TROLOX | |
|---|---|---|---|---|---|---|---|
| IC50 (mg/mL) | Human | 3.24 ± 0.38 | 3.56 ± 0.45 ns | 3.30 ± 0.65 ns | 3.26 ± 0.38 ns | 0.64 ± 0.06 | 0.58 ± 0.07 |
| Bovine | 4.10 ± 0.56 | 3.74 ± 0.53 | 4.38 ± 0.56 | 3.88 ± 0.49 | - | - | |
| TEAC | Human | 0.16 ± 0.05 ns | 0.16 ± 0.06 ns | 0.17 ± 0.04 ns | 0.17 ± 0.03 ns | 0.90 ± 0.05 | 1 |
| Bovine | 0.14 ± 0.04 | 0.15 ± 0.06 | 0.13 ± 0.05 | 0.15 ± 0.04 | - | - | |
| Hemoglobin Fractions (µg/mL) | ||||||||||||||||||
|---|---|---|---|---|---|---|---|---|---|---|---|---|---|---|---|---|---|---|
| Bacteria strains | 1 | 2 | 3 | 4 | 5 | 6 | 7 | 8 | 9 | |||||||||
| B | H | B | H | B | H | B | H | B | H | B | H | B | H | B | H | B | H | |
| Kocuria rhizophila | 1 | 1 | 2 | 2 | 4 | 4 | 2 | 4 | 2 | 1 | 2 | 4 | 4 | 4 | 8 | 4 | 2 | 2 |
| Staphylococcus aureus | 2 | 2 | 4 | 4 | 4 | 8 | 2 | 4 | 2 | 2 | 2 | 4 | 8 | - | - | - | 8 | 4 |
| Listeria monocytogenes | 1 | 1 | 625 | 625 | 8 | 8 | 4 | 4 | 4 | 4 | 2 | 4 | 8 | 8 | - | - | 4 | 4 |
| Escherichia coli | 8 | 8 | 4 | 8 | 4 | 4 | 4 | 4 | 15.6 | 8 | 4 | 4 | 8 | 15.6 | 8 | 4 | 310 | 310 |
| Salmonelle Newport | 4 | 4 | 625 | 625 | 2 | 4 | 4 | 4 | 4 | 4 | 8 | 15.6 | 310 | 310 | 8 | - | 4 | 4 |
| Micrococcus luteus | 8 | 8 | 2 | 4 | - | 8 | 2 | 4 | 4 | 4 | 8 | 4 | - | - | 8 | 8 | 625 | 625 |
| Fraction (min) | Position | Sequence | Molecular Weight (Da) | Bovine | Human | |
|---|---|---|---|---|---|---|
| Antimicrobials | 1 (6–8) | α137-141 | TSKYR | 653 | + | + |
| 2 (8–10) | α99-105 | KLLSHSL | 796 | + | KLLSHCL | |
| α100-105 | LLSHSL | 668 | + | - | ||
| 3 (10–15) | α99-106 | KLLSHSLL | 910 | + | KLLSHCLL | |
| 4 (15–20) | α133-141 | STVLTSKYR | 1054 | + | + | |
| 6 (25–30) | α37-46 | PTTKTYFPHF | 1238 | + | + | |
| α36-45 | FPTTKTYFPH | 1238 | + | + | ||
| α32-41 | FLSFPTTKTY | 1204 | - | + | ||
| 7 (30–35) | α34-46 | LSFPTTKTYFPHF | 1585 | + | - | |
| α33-46 | FLSFPTTKTYFPHF | 1732 | + | - | ||
| Anti-oxydant | α137-141 | TSKYR | 653 | + | + | |
Disclaimer/Publisher’s Note: The statements, opinions and data contained in all publications are solely those of the individual author(s) and contributor(s) and not of MDPI and/or the editor(s). MDPI and/or the editor(s) disclaim responsibility for any injury to people or property resulting from any ideas, methods, instructions or products referred to in the content. |
© 2023 by the authors. Licensee MDPI, Basel, Switzerland. This article is an open access article distributed under the terms and conditions of the Creative Commons Attribution (CC BY) license (https://creativecommons.org/licenses/by/4.0/).
Share and Cite
Outman, A.; Deracinois, B.; Flahaut, C.; Diab, M.A.; Dhaouefi, J.; Gressier, B.; Eto, B.; Nedjar, N. Comparison of the Bioactive Properties of Human and Bovine Hemoglobin Hydrolysates Obtained by Enzymatic Hydrolysis: Antimicrobial and Antioxidant Potential of the Active Peptide α137-141. Int. J. Mol. Sci. 2023, 24, 13055. https://doi.org/10.3390/ijms241713055
Outman A, Deracinois B, Flahaut C, Diab MA, Dhaouefi J, Gressier B, Eto B, Nedjar N. Comparison of the Bioactive Properties of Human and Bovine Hemoglobin Hydrolysates Obtained by Enzymatic Hydrolysis: Antimicrobial and Antioxidant Potential of the Active Peptide α137-141. International Journal of Molecular Sciences. 2023; 24(17):13055. https://doi.org/10.3390/ijms241713055
Chicago/Turabian StyleOutman, Ahlam, Barbara Deracinois, Christophe Flahaut, Mira Abou Diab, Jihen Dhaouefi, Bernard Gressier, Bruno Eto, and Naïma Nedjar. 2023. "Comparison of the Bioactive Properties of Human and Bovine Hemoglobin Hydrolysates Obtained by Enzymatic Hydrolysis: Antimicrobial and Antioxidant Potential of the Active Peptide α137-141" International Journal of Molecular Sciences 24, no. 17: 13055. https://doi.org/10.3390/ijms241713055
APA StyleOutman, A., Deracinois, B., Flahaut, C., Diab, M. A., Dhaouefi, J., Gressier, B., Eto, B., & Nedjar, N. (2023). Comparison of the Bioactive Properties of Human and Bovine Hemoglobin Hydrolysates Obtained by Enzymatic Hydrolysis: Antimicrobial and Antioxidant Potential of the Active Peptide α137-141. International Journal of Molecular Sciences, 24(17), 13055. https://doi.org/10.3390/ijms241713055

